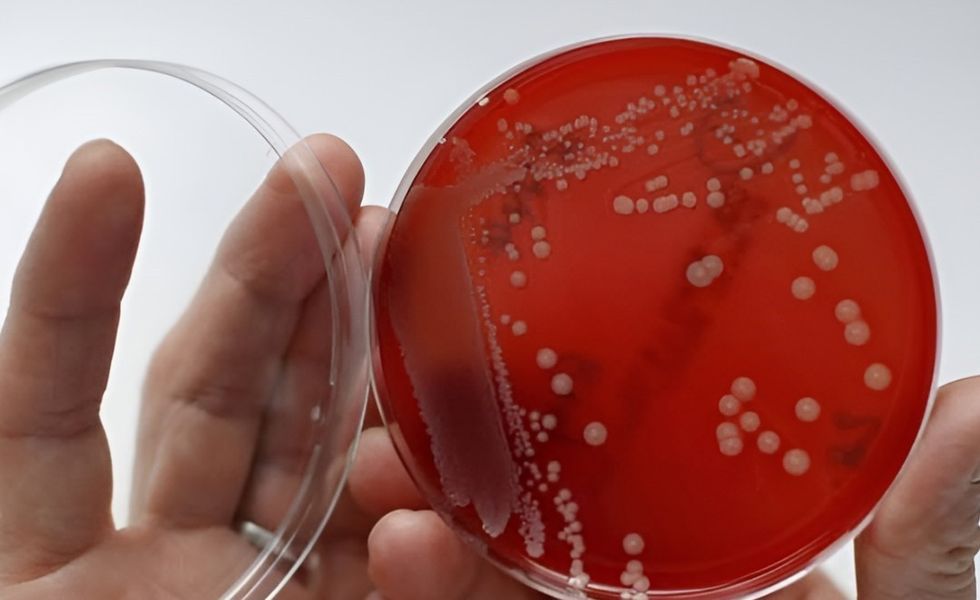

Një recetë 1,000-vjeçare që sfidon superbakteret moderne: Çfarë zbuloi shkenca?

Një ilaç i lashtë i përshkruar në dorëshkrimin anglo-sakson Bald’s Leechbook, një nga tekstet më të hershme mjekësore të Britanisë, ka rezultuar të jetë jashtëzakonisht efektiv kundër MRSA-së, një prej superbaktereve më rezistente ndaj antibiotikëve sot
Studiuesit e University of Nottingham, të udhëhequr nga ekspertja e anglishtes së vjetër Dr. Christina Lee, përkthyen recetën e një “ilaçi për sytë” dhe e rikrijuan me përpikmëri sipas udhëzimeve të dorëshkrimit: hudhër, qepë ose presh, verë dhe bilë nga stomaku i lopës, të përgatitura në një enë metalike dhe të lëna në temperaturë të ulët për nëntë ditë.
Rezultatet i habitën të gjithë.
Efektshmëria mahnitëse kundër MRSA
Ekipi i mikrobiologëve testoi recetën në kultura bakteriale dhe në modele plagësh të infektuara, përfshirë biofilmat, struktura të dendura bakteriale që janë zakonisht shumë rezistente ndaj trajtimit. Ndërsa secili përbërës veç e veç nuk tregoi pothuajse asnjë efekt, kombinimi i tyre sipas recetës mesjetare eliminoi deri në 90% të baktereve MRSA.
Dr. Freya Harrison e përshkroi rezultatin si “absolutisht i pabesueshëm”, duke theksuar se ilaçi arriti të depërtojë edhe biofilmat, aty ku shumë antibiotikë modernë dështojnë. Testimet e mëtejshme në universitetet amerikane treguan se ky preparat veproi po aq mirë, madje edhe më mirë se disa trajtime konvencionale kundër infeksioneve të vështiram, shkruan BBC, përcjell Telegrafi.

A ishte shkenca mesjetare më e avancuar se sa mendonim?
Zbulimi ka hapur një debat intriguese: a ndoqën mjekët anglo-saksonë një formë të hershme të metodës shkencore?
Dorëshkrimet e epokës përmbajnë dhjetëra receta për infeksione të syve, lëkurës, plagëve dhe probleme respiratorë, shumë prej tyre që sot i njohim si infeksione bakteriale. Përzgjedhja e përbërësve, mënyra e përgatitjes dhe kërkesa për ruajtje disa ditore sugjerojnë një nivel surprizues eksperimentimi dhe vrojtimi, shekuj para se njerëzit ta dinin çfarë ishin bakteret.
“Mesjeta mund të na mësojë ende shumë për luftën ndaj rezistencës antimikrobiale”, thotë Dr. Lee. “Këto tekste nuk mund të kuptohen plotësisht pa bashkimin e dijeve historike dhe shkencore.”
Përtej vrasjes së baktereve: si funksionon ilaçi?
Kur u hollua, preparati nuk i vriste më bakteret, por ndërhynte në komunikimin ndërqelizor, mekanizëm që bakteret përdorin për të aktivizuar gjenet e virulencës. Bllokimi i këtij komunikimi është një strategji moderne që po studiohet gjerësisht si mënyrë e re për të luftuar infeksionet pa shkaktuar rezistencë.
Ky efekt i dyfishtë, shkatërrimi i baktereve dhe ndërprerja e sinjaleve të tyre, e bën recetën një kandidat të jashtëzakonshëm për kërkime të mëtejshme.
Një urë mes së kaluarës dhe së ardhmes së mjekësisë
Projekti AncientBiotics është tashmë një shembull se si bashkëpunimi ndërdisiplinor mes filologjisë, historisë, mikrobiologjisë dhe mjekësisë moderne, mund të çojë në zbulime reale shkencore. Në një epokë kur rezistenca ndaj antibiotikëve është një kërcënim global, çdo gjurmë e errësuar nga e kaluara mund të shndërrohet në pistë shpëtimtare.
Studiuesit po vazhdojnë punën për të kuptuar mekanizmin e saktë të veprimit të ilaçit, për të përsëritur rezultatet dhe për të testuar mundësinë e zhvillimit të trajtimeve të reja të bazuara në këtë recetë të jashtëzakonshme mesjetare.

Pse kjo histori ka rëndësi?
- MRSA dhe superbakteret po bëhen gjithnjë e më të vështira për t’u trajtuar.
- Antibiotikët e rinj janë të paktë dhe kërkimi i tyre shumë i kushtueshëm.
- Mjekësia mesjetare, e cila shpesh shihet me skepticizëm, mund të përmbajë njohuri të vlefshme të humbura.
Ky zbulim sugjeron se e ardhmja e mjekësisë mund të gjendet edhe në tekstet 1,000-vjeçare, nëse kemi sy t’i lexojmë dhe shkencë t’i rikrijojmë. /Telegrafi/

















































